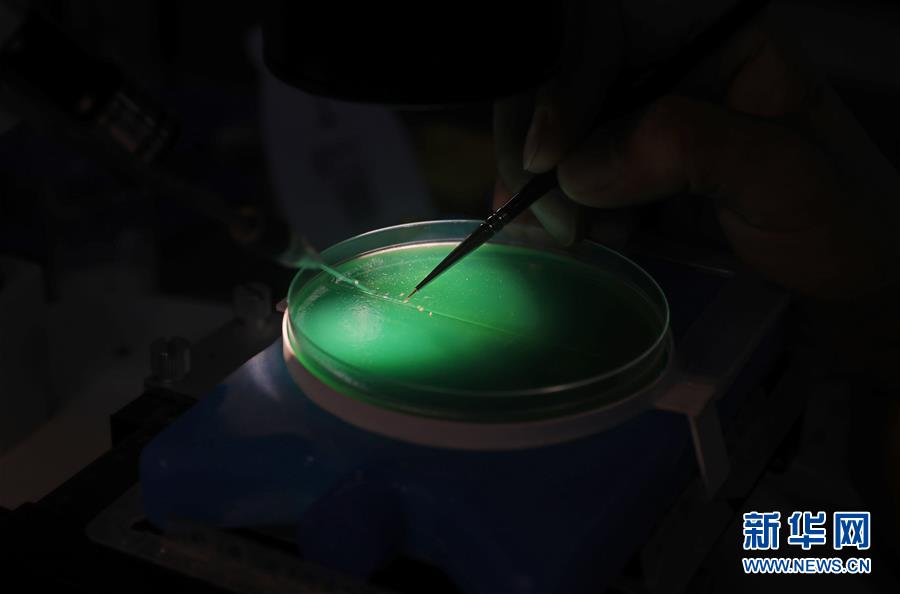

-
陕西启动职业教育服务乡村振兴战略三年行动计划
行动计划以产教融合为原则,以“四计划、一工程”为抓手,力争经过3年努力,形成职业教育服务“产业兴旺、生态宜居、乡风文明、治理有效、生活富裕”的全链条,实现职业教育与乡村振兴同频互动、高质量发展。
-
就业教学无缝对接
8月2日,山东水利技师学院智能制造系电工高级工一体化教学课上,教师正在指导学生进行机床控制线路安装与调试技能训练。据悉,该院以就业为导向,大力推进“校企双制、工学一体”教学,校企共育技能人才,实现学生凭高技能、真本事就业。
8月3日,在沈阳农业大学植物保护学院,昆虫专业的研究生在实验室进行昆虫显微注射。 进入暑假以来,沈阳农业大学的研究生们紧抓暑假空闲时间,在学校实验室、农业教学科研基地、自习室等地做实验、查资料、写论文。学校在做好疫情防控的同时,保障研究生学习和生活有序进行。 新华社记者 杨青 摄
行动计划以产教融合为原则,以“四计划、一工程”为抓手,力争经过3年努力,形成职业教育服务“产业兴旺、生态宜居、乡风文明、治理有效、生活富裕”的全链条,实现职业教育与乡村振兴同频互动、高质量发展。
8月2日,山东水利技师学院智能制造系电工高级工一体化教学课上,教师正在指导学生进行机床控制线路安装与调试技能训练。据悉,该院以就业为导向,大力推进“校企双制、工学一体”教学,校企共育技能人才,实现学生凭高技能、真本事就业。
如今,不少高校都开始为本科生配备导师,这些导师不仅有“青椒”,还有长江学者、院士等“学术大咖”。
近日,一位考上清华的“学霸”小伙,在网络上走红。当我们讨论“考上清华、工地搬砖”时,关注点可以比感动多一些。



×